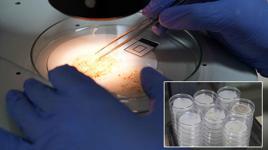

00:35Silivri'de otluk alanda çıkan yangın söndürüldü; 3 kişi dumandan etkilendi
00:35Silivri'de otluk alanda çıkan yangın söndürüldü; 3 kişi dumandan etkilendiMikroplastik tehlikesi gözle görülmüyor, hayatı tehdit ediyor
Akdeniz Üniversitesi Su Ürünleri Fakültesi'nden Doç. Dr. Olgaç Güven, mikroplastik sorununu anlamak için kaynağa inmek gerektiğini söyledi. Plastik atıkların büyük kısmının karasal faaliyetlerden kaynaklandığını aktaran Doç. Dr. Güven, bu atıkların yağmur suları, akarsular ve kanalizasyon sistemleriyle denize ulaştığını söyledi. Bu sürecin sonunda deniz çöpü olarak adlandırılan ciddi kirlilikle karşılaşıldığını vurgulayan Doç. Dr. Güven, "Deniz çöplerinin yaklaşık yüzde 80'ini plastikler oluşturuyor. Bunun dışında cam, metal, tekstil ve ahşap atıklar da var ama baskın tehdit plastik" diye konuştu.
DENİZ CANLILARI PLASTİK YİYOR, TEKNELER ZARAR GÖRÜYOR
Plastik atıkların sadece çevresel değil, sosyoekonomik sonuçlar doğurduğunu da belirten Doç. Dr. Güven, "Kaplumbağalar ve deniz memelileri bu atıkları besin sanarak yutabiliyor. Sindirim sistemlerinde tıkanma ve ölümler meydana geliyor. Yüzeyde biriken atıklar ise balıkçı teknelerinin pervanelerine dolanarak maddi zararlara neden oluyor. Avrupa denizlerinde bu nedenle milyonlarca avro kayıp yaşanıyor" dedi.
Plastiklerin zamanla fiziksel, kimyasal ve biyolojik etkilerle parçalanarak mikroplastiğe dönüştüğünü aktaran Doç. Dr. Güven, "Mikroplastikler ya büyük plastiklerin parçalanmasıyla ya da kozmetik, tekstil gibi sektörlerde bilinçli üretilen ürünlerle oluşuyor. Peeling losyonlar, diş macunlarındaki tanecikler veya tekstil fiberleri bu kapsama giriyor. Arıtma tesislerinden geçen bu parçacıklar doğrudan denize karışabiliyor" dedi.
HER DENİZİN KİRLİLİK SEVİYESİ FARKLI
Türkiye'nin 4 denizi arasında en riskli bölgelerin Marmara ve Karadeniz olduğuna dikkati çeken Doç. Dr. Güven, Marmara Denizi'nin sanayi ve nüfus baskısı altında olduğunu, Susurluk Havzası gibi alanlardan ciddi kirletici yük aldığını söyledi. Karadeniz'e ise Avrupa'dan gelen nehirler yoluyla ciddi plastik yükü taşındığını belirten Doç. Dr. Güven, "Her denizin kirlilik seviyesi farklılık gösteriyor. Akdeniz ve Ege daha açık sistemler olduğu için kirleticiler daha hızlı seyrelse de bu, sorun yok anlamına gelmez. Özellikle Akdeniz'in doğu kıyıları, Seyhan ve Ceyhan nehirleri aracılığıyla ciddi kirlilik baskısı altında" diye konuştu.
Plastik kirliliğinin diğer atık türlerinden farklı olduğunu vurgulayan Doç. Dr. Güven, “Bu atıklar doğada çözülmüyor, yok olmuyor. Sadece parçalanarak daha küçük boyutlara iniyorlar. Mikro boyuttan nano boyuta kadar inen bu parçacıklar sonunda fitoplankton gibi besin zincirinin tabanındaki canlılara kadar ulaşarak insanı da tehdit ediyor" dedi.
'HAREKETE GEÇMEZSEK DENİZLER YAŞANMAZ HALE GELECEK'
Avrupa'da yasaklanmaya başlanan tek kullanımlık plastiklere dikkati çeken Doç. Dr. Güven, "Tabak, pipet, çatal, kulak çubuğu gibi ürünler bir kez kullanılıp atılıyor ama doğada yıllarca kalıyor. Yaşam tarzımızı atık üretmeyecek şekilde yeniden tasarlamak zorundayız" uyarısında bulundu.
Çözüm önerilerini paylaşan Doç. Dr. Güven, bireysel farkındalık ve toplumsal katılımın önemine vurgu yaparak, "Sahillerde, doğada atık bırakmamalıyız. Sivil toplum girişimlerine destek vermeliyiz. Ancak hiçbir şey yapılmazsa plastik üretimi devam edecek, kullanıldıktan sonra atığa dönüşecek ve yok olmadan çevremizi tehdit etmeye devam edecek. Önlem almazsak yavaş yavaş kendi yaşam alanımızı yaşanmaz hale getireceğiz. Harekete geçmezsek denizler yaşanmaz hale gelecek" ifadelerini kullandı. (DHA)
 00:35Silivri'de otluk alanda çıkan yangın söndürüldü; 3 kişi dumandan etkilendi
00:35Silivri'de otluk alanda çıkan yangın söndürüldü; 3 kişi dumandan etkilendi 11:13Midyat mutfağı ve el sanatları, kadın emeğiyle turizme kazandırılıyor
11:13Midyat mutfağı ve el sanatları, kadın emeğiyle turizme kazandırılıyor 05:07Üniversite öğrencilerinden GPS sinyali olmadan çalışan İHA
05:07Üniversite öğrencilerinden GPS sinyali olmadan çalışan İHA 01:14Ayı ile 3 yavrusu Kösedağ'ın zirvesinde dronla görüntülendi
01:14Ayı ile 3 yavrusu Kösedağ'ın zirvesinde dronla görüntülendi 07:51İHA teknolojisi eğitimi için Türkiye’yi seçen Ekaterina, takımıyla dünya 3’üncüsü oldu
07:51İHA teknolojisi eğitimi için Türkiye’yi seçen Ekaterina, takımıyla dünya 3’üncüsü oldu 03:13Diyalize bağlı geçen 30 yıldan sonra hem böbreğine hem de özgürlüğüne kavuştu
03:13Diyalize bağlı geçen 30 yıldan sonra hem böbreğine hem de özgürlüğüne kavuştu 02:19Şişli’de sokakta taciz iddiası; şüpheli fırında ekmek yaparken yakalandı: 'Lütfen sesinizi çıkarın'
02:19Şişli’de sokakta taciz iddiası; şüpheli fırında ekmek yaparken yakalandı: 'Lütfen sesinizi çıkarın' 04:01İzmirli şampiyon judocuların hedefi Avrupa'da madalya
04:01İzmirli şampiyon judocuların hedefi Avrupa'da madalya